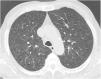

Intravesical Bacillus Calmette-Guérin (BCG) instillation is a mainstay of adjunctive therapy for superficial bladder cancer that increases length of disease progression-free survival. Although usually well tolerated, moderate to severe local and systemic infectious complications can occur with this immunotherapy. Diagnosis is difficult and often based on high clinical suspicion since in many cases Mycobacterium bovis is not isolated. Treatment is not fully standardized but the combination of anti-tuberculosis drugs and corticosteroids is advocated in severe cases.
The authors present an unusual case of a severe infectious complication following intravesical BCG instillation with pulmonary and kidney involvement. Prompt anti-tuberculosis treatment associated to corticosteroid resulted in a marked clinical and radiological improvement, supporting the diagnosis of disseminated BCG infection. Based on this, the authors aimed to review the literature on this exceptional complication of this immunotherapy.
Intravesical instillation of bacillus Calmette-Guérin (BCG), a live attenuated strain of Mycobacterium bovis, is an efficient immunotherapy for superficial bladder cancer, which is associated with increased length of disease progression-free survival.1 The BCG therapy is usually well tolerated, with some minor side effects reported, generally self-limiting without specific treatment.2
Serious adverse events are uncommon (less than 5%) and are usually related to disseminated BCG infection (<1%).3 Its diagnosis is challenging since at least half of the cases do not yield positive microbiological results.1,4 Sepsis is its most fulminant manifestation but infection of several organs, such as the liver or the bone, can arise. Pulmonary involvement is very rare (0.3–0.7% of the cases), usually presenting as interstitial pneumonitis or miliary dissemination.5
In this manuscript, we report a rare case of a patient with a disseminated infection with pulmonary involvement after BCG intravesical instillation, and conduct a narrative review of the literature on this topic.
Case reportA 69-year-old man, with history of hypertension and dyslipidemia, was diagnosed with high-grade bladder urothelial carcinoma (pT1). A transurethral resection of the bladder was performed, followed by mensal BCG intravesical instillation in the last 18 months, without major adverse reactions except flu-like symptoms lasting less than 48 h after each dose. Two days after the last instillation, he presented macroscopic hematuria and severe fatigue, sweating and persistent non-productive cough. Eight days later, due to the persistence of symptoms and the appearance of dyspnea and fever, he went to the emergency department. He had no recent sick or tuberculosis contacts. On admission, he was febrile (38.3 °C), hypotensive (89/40 mmHg), in respiratory distress with inspiratory crackles in both lungs. Arterial blood gas analysis showed, in ambient air, hypoxemia [partial pressure of oxygen 63 mmHg) and respiratory alkalosis. Laboratory tests revealed mild anemia (hemoglobin 11.9 g/dL) with normal white blood cell and platelet count, increased levels of C-reactive protein (10.9 mg/dL) and erythrocyte sedimentation rate (57 mm/h), acute kidney injury [serum creatinine (sCr) 2.35 mg/dl], hematuria, leukocyturia and proteinuria. Serological tests were negative for hepatitis B and C and human immunodeficiency virus. Markers of immune-mediated disease (antinuclear, antineutrophil cytoplasmic, antiglomerular basement membrane and anti-streptolysin O antibodies) were all negative. Serum immunoglobulins and complement levels were normal. The chest radiography showed a bilateral reticulonodular infiltrate (Fig. 1) and the thoracic computed tomography (CT) demonstrated a diffuse pulmonary micronodulation, in a miliary pattern (Fig. 2). Renal ultrasonography revealed normal-sized kidneys with a reduced corticomedullary differentiation. Specimens for microbiological exam were collected and empirical broad-spectrum antibiotic treatment was started. On the fifth day of treatment, both fever and acute respiratory failure persisted, lung opacities were unmodified and renal function worsened (sCr 3.52 mg/dL). Multiple cultures of sputum, urine and blood were negative for both bacteria and mycobacteria, including polymerase chain reaction (PCR). A bronchoscopy with bronchoalveolar lavage (BAL) was performed which revealed a prevalence of lymphocytes (48.2%) and an elevated CD4/CD8 ratio (11), absence of malignant cells and bacteriological and mycobacteriological exams were negative. Due to the lack of clinical and imagiological improvement, the diagnosis of disseminated BCG infection was suggested and empiric anti-tuberculosis treatment (ATT) [isoniazid 300 mg, rifampin 600 mg and ethambutol 1200 mg; once daily] associated with a corticosteroid (prednisolone 60 mg once daily) was started and, few days later, patient’s clinical condition improved, with sustained apyrexia, resolution of acute respiratory failure and slow but steady recovery of renal function. He was discharged in good general condition and continued ATT for 6 months. Steroids were discontinued tapering down the dosage for 5 months. A high-resolution CT scan of thorax, performed 6 months after discharge, showed almost complete resolution of the lung opacities with a reduction in the number and size of bilateral pulmonary nodules (Fig. 3) and kidney function was fully recovered (sCr 0.86 mg/dL). BCG immunotherapy was discontinued. No sign of relapse was observed after one year of follow-up.
DiscussionBCG immunotherapy provides the best risk-benefit therapy in patients with high-risk superficial bladder cancer and isthe most commonly used and effective adjunctive therapy for this malignancy.2 Several studies have shown that intravesical BCG is more effective than intravesical chemotherapy.6 BCG infusions promote an immunomodulatory process characterized by a local immune activation involving a multitude of cytokines and local migration of polymorphonuclear cells, ultimately leading to the death of tumor cells.7 Due to this inflammatory challenge, minor side effects are commonly reported including genitourinary symptoms, such as cystitis (91%), macroscopic hematuria (1%), bladder contracture (0,2%), granulomatous prostatitis (0,9%), epididymo-orchitis (0,4%) and urethral obstruction (0,3%). Low-grade fever, malaise and chills following instillation are also common and usually self-limiting within a few hours or days.3,7 Serious adverse events were reported in less than 5% of over 2600 patients treated with BCG instillations, which include pneumonitis or hepatitis (0,7%), cytopenia (0,1%) and sepsis (0,4%).3 Similar results were described in a pooled analysis of case reports8 and in a recent retrospective review9 that revealed an incidence of BCG infection of 4.3% and 1.3%, respectively.
Disseminated BCG infection, also referred as “BCGitis”, should be suspected in any patient who develops moderate-to-severe genitourinary or systemic symptoms, following ≥1 instillation of intravesical BCG, responding to ATT and with no alternative diagnosis. Microbiologic or histopathologic evidence of mycobacterial infection is not necessary for diagnosis.8
In our patient, dissemination of M. bovis developed following an intravesical BCG instillation. Although mycobacterial identification was not achieved, a presumptive diagnosis of disseminated BCG was justified by the clinical presentation consistent with active tuberculosis, associated with radiological findings consistent with pulmonary spread of M. bovis. Additionally, the evidence of macroscopic hematuria and acute kidney injury suggested an initial regional effect with generalized “BCGitis” coursed with pneumonitis.
The lack of mycobacterial identification is not unusual since, as pointed out by a recent review, serological tests and cultures are negative in approximately 60% of cases, being useful especially for differential diagnosis.8 The exclusion of an alternative diagnosis and the prompt response to treatment should be considered the cornerstones of BCGitis diagnosis, as we observed in our patient.
Risk factors for disseminated infection include host characteristics, such as the extent of bladder mucosal damage and immunodeficiency, which are considered more important than therapeutic regimen features.8,10 Our patient received 18 BCG instillations without major complications but this repeated exposure may have predisposed him to subsequent dissemination, although dissemination can occur at any time in the course of treatment.8 Interestingly, all reported cases of disseminated BCG infection treated with BCG immunotherapy occurred in males, suggesting a potential influence of sex hormones in this susceptibility.11
Pulmonary involvement is very rare and can present as hypersensitivity or mycobacterial pneumonia. Hypersensitivity is usually characterized by an interstitial pattern in chest x-ray and lymphocytosis on BAL.12 Miliary pattern nodules in lung parenchyma is rarely reported in the literature. An extensive and systematic review of the literature, retrieved 26 published cases11–36 (Table 1) which provide a comprehensive clinical, radiological and microbiological information of miliary tuberculosis caused by disseminated BCG infection in adults treated with intravesical BCG immunotherapy.
Published cases of miliary tuberculosis caused by disseminated BCG infection in adults treated with intravesical BCG immunotherapy.
| Patient, reference | Journal, study design | Age, gender | Symptoms | No. of BCG instillations | Pathological findings | Microbiological diagnosis | Treatment; duration (months) | Outcome |
|---|---|---|---|---|---|---|---|---|
| 1, Gupta et al., 1988 13 | Chest; CR | 78, M | Fever, cough | 10 | NCG | All negative | INH, RIF, EMB (9) | Resolution |
| 2, Kesten et al., 1990 14 | Thorax; CR | 67, M | Fever, weight loss | 4 | NCG | All negative | INH, RIF NS | Resolution |
| 3, Baloira Villar et al., 1992 15 | Med Clin (Barc); CR | 78, M | Fever, weight loss,haemoptysis | 5 | CG | Acid fast stain | INH, RIF, PZA (6) | Resolution |
| 4, McParland et al., 1992 16 | Am Rev Respir Dis; CR | 69, M | Fever, chills, cough | 6 | NCG | Culture M.bovis (lung biopsies) | INH, RIF, PZA, STM, steroids; (12) | Resolution |
| 5, Smith et al., 1993 17 | Cancer; CR | 69, M | Asymptomatic | 6 | CG | All negative | INH, RIF, PZA NS | Death |
| 6, Palayew et al., 1993 18 | Chest; CR | 57, M | Weight loss, cough, dyspnea | 10 | NCG | Acid fast stain | INH, RIF,EMB steroids; (9) | Resolution |
| 7, Jasmer et al., 1996 19 | Radiology; CR | 73, M | Fever, weight loss | 9 | CG | All negative | INH, RIF, EMB (9) | Resolution |
| 8, Paredes et al., 1996 20 | Arch Bronconeumol;CR | 67, M | Fever, chills | 14 | CG | All negative | INH, RIF, EMB NS | Death |
| 9, Iantorno et al., 1998 21 | J Uro; CR | 79, M | Fever, chills, cough, dyspnea | 8 | NCG | All negative | INH, RIF, EMB PZA; NS | Resolution |
| 10, Rabe et al., 1999 22 | AJR Am J Roentgenol; CR | 60, M | Fever, malaise, arthralgias | 16 | NCG | All negative | INH, RIF, EMB steroids; (3) | Resolution |
| 11, Elkabani et al., 2000 23 | Cancer Control; CR | 67, M | Fever, weakness, dyspnea | 16 | ND | All negative | INH, RIF, LEV steroids; (12) | Resolution |
| 12, Audigier et al., 2000 24 | Rev Mal Respir; CR | 69, M | Fever, dyspnea | 5 | NCG | All negative | INH, RIF steroids; (9) | Resolution |
| 13, Mignon et al., 2002 25 | J Radiol; CR | 76, M | Fever | 10 | ND | All negative | INH, RIF, EMB (6) | Resolution |
| 14, Toscano et al., 2003 26 | Eur J Clin Microbiol Infect Dis; CR | 72, M | Fever, weight loss, cough | 6 | NS | PCR M. tuberculosis complex | INH, RIF, EMB steroids; (12) | Resolution |
| 15, Castillo et al., 2006 27 | Med Intensiva; CR | 75, M | Fever, dyspnea | NS | Diffuse inflammator signs | PCR M. tuberculosis complex (BAL) | INH, RIF, EMB steroids; NS | Death |
| 16, Nadasy et al., 2008 28 | South Med J; CR | 62, M | Fever, malaise, cough | 3 | CG | Acid fast stain | INH, RIF, LEV steroids; (6) | Resolution |
| 17, Cobas Paz et al., 2010 29 | Arch Bronconeumol;CR | 62, M | Asymptomatic | 6 | NCG | All negative | INH, RIF, EMB (6) | Resolution |
| 18, Colmenero et al., 2012 30 | Diagn Microbiol Infect Dis; CR and Review | 56, M | Fever, chills, malaise, cough | 9 | ND | PCR M. tuberculosis complex (BAL) | INH, RIF steroids; (9) | Resolution |
| 19, Caramori et al., 2013 11 | Monaldi Arch Chest Dis; CR and Review | 66, M | Fever, dyspnea | 18 | NCG | PCR M. tuberculosis complex (BAL) | INH, RIF, EMB PZA, steroids; (9) | Resolution |
| 20, Choi CR et al., 2014 31 | BMJ Case Rep; CR | 51, M | Weakness, weight loss | 5 | NCG | All negative | INH, RIF, EMB NS | Resolution |
| 21, Venn et al., 2014 32 | BMJ Case Rep; CR | 74, M | Fever, night sweats, anorexia | 7 | ND | All negative | None | Resolution |
| 22, Rosati et al., 2016 12 | Urologia; CR | 63, M | Fever, cough | 6 | NCG | All negative | INH, RIF, EMB steroids; (9) | Resolution |
| 23, Smith et al., 2016 33 | BMJ Case Rep; CR | 69, M | Cough, night sweats, weight loss | NS | ND | All negative | INH, RIF, EMB (9) | Resolution |
| 24, Calleris et al., 201734 | Le Infezioni in Medicina; CR | 73, M | Fever, weakness, night sweats | NS | ND | PCR M. tuberculosis (sputum) | INH, RIF, EMB NS | Resolution |
| 25, Kaburaki et al., 201735 | Intern Med; CR | 62, M | Fever, fatigue | 8 | NCG | All negative | INH, RIF, EMB steroids; (9) | Resolution |
| 26, Clérigo et al., 201936 | Acta Med Port; CR | 67, M | Fever | 6 | NCG | All negative | INH, RIF, EMB steroids; (12) | Resolution |
Abbreviations: BALBronchoalveolar cultures; CGCaseating granuloma; CRcase report; EMBEthambutol; INHIsoniazid; LEVLevofloxacin; Mmale; NCGNoncaseating granuloma; NSNot specified; NDNot done; PCRpolymerase chain reaction; PZAPyrazinamide; RIFRifampin; STMStreptomycin. [Obtained with the data from Refs.10–33
The diagnosis can be confirmed by the presence of epithelio-giganto-cellular granulomas with or without caseous necrosis in bronchial or pulmonary biopsy. However, since they are present in only 40% of biopsies, in most of the cases they do not contribute to the diagnosis.37 As previously reported, caseous necrosis is usually absent (Table 1). Pulmonary parenchymal changes also include fibrosis of the lung and lymphocytic alveolar infiltrates consistent with hypersensitivity alveolitis. BAL cellular profile usually shows lymphocytosis with an elevated CD4/CD8 ratio consistent with a T helper alveolitis,38 as we documented in our patient.
Although its pathogenesis is not fully understood, some authors believe that BCGitis is caused by hypersensitivity reactions and the granulomas are due to type 4 hypersensitivity reaction and not infection, supported by the negative results of cultures and of serological and molecular tests, along with successful response to steroids.12,22–24,35,36 On the other hand, some case reports support the theory of an ongoing active BCG infection demonstrated by the presence of viable bacilli inside the lesions16 or detection of mycobacterial genome by Polymerase Chain Reaction assays,11,26,27,30,34 that require specific treatment. This supports the absence of a standardized treatment for BCG complications.
In our case, it can be argued that patient’s symptoms were due to hypersensitivity reaction, because of negative culture results from BAL as well as absence of acid-fast bacilli on direct microscopy, and also the BAL cellular profiles revealed lymphocytosis with an elevated CD4/CD8 ratio. However, due to the persistence and severity of clinical symptoms with respiratory failure, antituberculous were added to steroids with clinical improvement within 3 days. The speed of improvement suggests the more important role of hypersensitivity rather than infection.
Until now, trials done have not been good enough to determine the most effective treatment. In addition, in some case reports, simple discontinuation of BCG alone was sufficient. Venn et al. illustrated a case who had febrile illness for more than one month with persisting pulmonary nodules, that improved without any treatment. The authors suggested that some pulmonary reactions, with mild initial presentation, may resolve spontaneously, whether due to hypersensitivity or natural clearance of BCG.32
Nevertheless, in disseminated BCG infection, the combination of antimycobacterial therapy and corticosteroids is suggested.3M. bovis is inherently resistant to pyrazinamide and cycloserine, so a regimen that includes isoniazid and rifampin for 6 months with ethambutol for 2 months can be used. When liver toxicity is a concern, regimens including ethambutol, fluoroquinolones and amikacin have been proposed. The corticosteroid adjuvant therapy is particularly important where there is extensive miliary involvement and respiratory failure, but until now, no standardized regimen has been recommended.8 A retrospective review of eight cases revealed improvement with just steroid treatment in patients with clinical signs of hypersensitivity, including pneumonitis and hepatitis.39
Since no routine prophylaxis protocol has demonstrated long-term efficacy for systemic BCG infection prevention,32 most authors consider a previous systemic BCG infection a contraindication to restarting immunotherapy.9
The prognosis seems to be favourable in most patients when an appropriate therapy is started. Pérez-Jacoiste Asín et al.8 observed a 5,4% attributable mortality, generally due to respiratory, liver and multiple organ failure.
This case highlights the importance of recognizing disseminated BCG infection as a potential complication in patients with previous BCG exposure, but more studies are necessary not only to fully understand its pathogenesis but also to standardize the diagnosis and treatment.